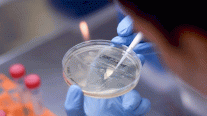
إنجاز لقاح في 100 يوم لأي فيروس طارئ

جنيف: أشادت مديرة منظمة التجارة العالمية الأربعاء بالتوصل الى تسوية بهدف التنازل عن براءات اختراع اللقاحات المضادة لكوفيد بين أربعة أطراف مصنعة كبرى داعية كافة الدول الأعضاء إلى دعم الخطوة.
وفي بيان لفت الى انه لم يتم إتمام كل تفاصيل التسوية بعد، أشارت نغوزي أوكونجو-إيويالا الى "التقدم الحاسم الذي أحرزه" الاتحاد الأوروبي والولايات المتحدة والهند وجنوب إفريقيا "بشأن التنازل عن الاتفاق حول الجوانب المتعلقة ببراءات الاختراع التي تطال انتاج لقاحات مضادة لكوفيد-19".
وأضافت "هذه خطوة كبيرة إلى الأمام وهذه التسوية هي نتيجة ساعات من المفاوضات الطويلة والصعبة".
وتابعت "لا يزال علينا أن نعمل من أجل ضمان الحصول على دعم كل أعضاء منظمة التجارة العالمية".
درجت الدول الأعضاء في منظمة التجارة العالمية على عادة اتخاذ القرارات بالتوافق وعبرت سويسرا عدة مرات عن تردد شديد إزاء مبدأ التنازل عن براءات الاختراع. وهو موقف يؤيده تجمع شركات الصيدلة.
المحادثات في منظمة التجارة العالمية حول مسألة براءات الاختراع والوصول الى اللقاحات في الدول الفقيرة، أطلقتها الهند وجنوب إفريقيا في 2020، السنة الأولى لوباء كوفيد-19.
لم يتم إحراز أي تقدم فعلي، وقد أطلقت هاتان الدولتان اللتان انضمت اليهما الولايات المتحدة والاتحاد الأوروبي، مجموعة مصغرة في كانون الأول/ديسمبر للتفاوض على تسوية.
في الأسابيع الماضية، كانت سويسرا الوحيدة التي انتقدت الخطوة علنا مؤكدة ان صيغة المجموعات الصغيرة لا تتوافق مع المبادئ الأساسية لمنظمة التجارة العالمية.
تفاصيل غير منجزة
أكدت أوكونجو-إيويالا التي تدعم في المقابل هذه العملية، الأربعاء ان التسوية التي تم التفاوض عليها بين الشركاء الأربعة تشكل "عنصرا أساسيا في أي اتفاق نهائي".
وحذرت أيضا من أن الاتحاد الأوروبي والولايات المتحدة والهند وجنوب إفريقيا لا يزال يجب أن تجري مشاورات وان كل تفاصيل التسوية لم تنجز بعد.
لكن مديرة منظمة التجارة العالمية طلبت أن يتم توسيع المحادثات حول هذا النص لتشمل كل الدول الأعضاء في المنظمة.
وقالت "في منظمة التجارة العالمية، نقرر بالتوافق ولم نصل بعد الى هذه المرحلة".
تعتبر عدة دول نامية تدعمها المنظمات غير الحكومية وبعض المنظمات الدولية بينها منظمة الصحة العالمية ان رفع براءات الاختراع أمر أساسي لتسهيل تقاسم أكبر للمعرفة.

التعليقات